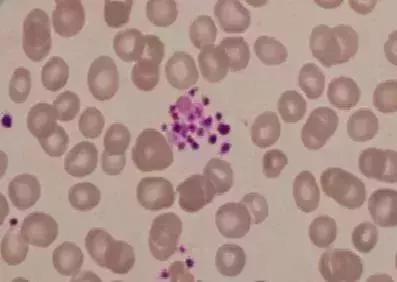
关于“检验报告”，这大概是最科学的一篇文章了

了解更多资讯,请关注医家小二微信公众号。
常见生化检验指标
1、甘油三酯
甘油三酯来自食物中脂肪的分解,在肝、脂肪组织及小肠合成,如果甘油三酯过量,囤积于皮下就会使身体肥胖,囤积于血管壁则造成动脉硬化,囤积于心脏就会导致心脏肥大,囤积于肝脏则会造成脂肪肝,是衡量身体是否健康的一个重要指标。

除了看医生,你还得?
1、清淡饮食,吃低脂食物,最好食用植物油。
2、多运动,快约起跑来。
2、高密度脂蛋白胆固醇
高密度脂蛋白胆固醇曾经被通俗地称为"好"胆固醇,可以减少患冠状动脉心脏病的危险。如果指标偏低,患动脉粥样硬化的危险性越大。近年来的临床研究指出:升高HDL-C水平并未带来心血管获益。目前指南对HDL-C的态度是:低HDL-C可作为ASCVD风险评估的危险因素,但不建议针对低HDL-C进行药物治疗。
3、低密度脂蛋白胆固醇
低密度脂蛋白胆固醇可通俗地理解为"坏"胆固醇,它的水平升高会增加患冠心病、诱发急性心肌梗死的概率。但这个指标不是越低越好,偏低可能是营养不良或得了慢性贫血等疾病。
4、血糖
血液中的糖分就是血糖。它偏高和偏低都会带来不良的影响。低血糖会引起记忆力减退、反应迟钝等症状,诱发脑血管意外,心律失常及心肌梗塞。高血糖则会引发血管病变、糖尿病等症状。
目前糖尿病的诊断标准为:
空腹血浆葡萄糖浓度≥7mmol/L,或口服葡萄糖耐量试验时2小时血浆葡萄糖浓度≥11.1mmol/L,或随机静脉血浆葡萄糖浓度≥11.1mmol/L,或糖化血红蛋白≥6.5%。
注意这四项是或者的关系,只要有一项不正常就认为是不正常。
5、糖化血红蛋白
糖化血红蛋白能够反映过去2~3个月血糖控制的平均水平,它不受偶尔一次血糖升高或降低的影响,因此对糖化血红蛋白进行测定,可以比较全面地了解过去一段时间的血糖控制水平。
6、糖化血红蛋白与血糖的控制情况
4%~6%:血糖控制正常。
6%~7%:血糖控制比较理想。
7%~8%:血糖控制一般。
8%~9%:控制不理想,需加强血糖控制,多注意饮食结构及运动,并在医生指导下调整治疗方案。
>9%:血糖控制很差,是慢性并发症发生发展的危险因素,可能引发糖尿病性肾病、动脉硬化、白内障等并发症,并有可能出现酮症酸中毒等急性合并症。
7、总蛋白
总蛋白主要用于判断营养状态、肝脏功能、肾脏功能、有无感染等。一般人的总蛋白会在一个合理区间内,假如超出这个区间,说明肝脏有一定的受损,需要结合其他指标做进一步检查判断。
8、谷丙转氨酶偏高
肝功检查中最基本、最重要的指标就是血清谷丙转氨酶。肝细胞发生炎症病变,引起细胞肿胀、坏死或肝细胞膜通透性增高等,均可使谷丙转氨酶释放于血液循环中,而使血清谷丙转氨酶增高。大量喝酒、食用某些食物也会引起肝功能短时间损害。
除了看医生,你还得?
1、调节情绪,不要过分紧张和焦虑,这样不利于指标的恢复。
2、戒酒,多食用富含维生素B和高蛋白的食物,能促进肝细胞的修复与再生。此还应注意新鲜蔬菜和水果的补充。
9、尿酸偏高
尿酸是体内嘌呤代谢的最终产物,经肾脏排出。尿酸高是人体内有一种叫做嘌呤的物质因代谢发生紊乱,致使血液中尿酸增多而引起的一种代谢性疾病。尿酸长期增高可致痛风及泌尿系统结石和肾功损害。
除了看医生,你还得?
1、注意少进食动物内脏、海鲜、啤酒、火锅等高嘌呤的食物。2、每日饮水大于2000ml以上,有助于降低尿酸。
血常规指标
1、红细胞
红细胞是血液运送氧气的最主要的媒介,同时还具有免疫功能。如果体检发现红细胞增高,首先得思考提前几天是否有过禁(脱)水、重体力劳动、高原旅游等情况,这些都会引起红细胞异常。但也不排除红细胞增多症、各种先天性心脏病、慢性肺疾病造成的指标异常。检验医学网
2、红细胞体积分布宽度
红细胞体积分布宽度是反映红细胞大小的一项指标。贫血时红细胞体积分布宽度升高,缺铁性贫血红细胞体积分布明显升高,如红细胞体积分布宽度正常者,缺铁性贫血可能性不大,故常作为缺铁性贫血的筛选。如果此项指标异常,需就医结合平均红细胞体积、平均红细胞体积等指标进行综合评估。
3、白细胞

血液中的白细胞俗称“白血球”,包括中性粒细胞、嗜酸性粒细胞、嗜碱性粒细胞、淋巴细胞和单核细胞。化验单中白细胞计数是指测定血液中白细胞的总数,分类是指计算上述各类白细胞的百分比。在不同的疾病状况下,可引起不同类型白细胞的数量变化。医生会根据白细胞的数量及百分比的变化来判断病因。
白细胞是人体与疾病斗争的“卫士”,当病菌侵入人体体内时,白细胞能通过变形而穿过毛细血管壁,集中到病菌入侵部位,将病菌包围﹑吞噬。如果体内的白细胞的数量高于正常值,很可能是身体有了炎症。白细胞值增高常见于急性细菌感染等;白细胞值降低则常见于病毒感染等。
4、血小板
血小板是是从骨髓成熟的巨核细胞胞质裂解脱落下来的具有生物活性的小块胞质,具有止血凝血等功能。
血小板的主要功能是止血和凝血、修补破损血管。
血小板若低于正常值:必须加以重视,因为它可能提示很多疾病,如免疫性血小板减少症、脾功能亢进、再生障碍性贫血、急性白血病等。
血小板若高于正常值:可能预示了原发性血小板增多症、也可见于各种慢性感染或肿瘤等疾病。
5血红蛋白
血红蛋白是红细胞内参与氧气运输的一种蛋白质,铁、叶酸、维生素B12是其合成的重要原料。正常男性为(120~160) g/L,女性为(110~150) g/L。
血红蛋白低于正常水平称之为贫血,可见于多种疾病:①造血原料不足引起的缺铁性贫血,营养不良性贫血。②骨髓造血功能衰竭如再生障碍性贫血。③各种急性、慢性失血所致红细胞丢失过多如严重外伤失血、溃疡病出血、月经过多、痔疮或肛裂出血。④红细胞破坏过多引起的各种溶血性贫血。⑤恶性肿瘤细胞侵犯骨髓,如各种白血病、骨髓瘤、骨髓转移癌等。
如发现血红蛋白结果异常,应注意查看是否同时伴有白细胞数、血小板及网织红细胞数目异常,必要时应做骨髓穿刺检查,因为这些数据对于进一步明确贫血的病因非常重要。同时应听从血液科医师的指导,不可自作主张乱服药,以免延误诊治。
肿瘤标志物指标

肝癌中,CA19-9、AFP等升高要引起注意;
乳腺癌中,CA15-3和CA125升高要特别重视;
肺癌中,由于肺癌组织类型有多种,其标志物的特异性也有所区别,腺癌主要是CEA升高,鳞癌主要是SCC升高,小细胞肺癌主要是NSE和ProGRP升高;
女性盆腔肿瘤主要是CA125和HE4升高;
胃肠肿瘤主要是CA19-9和CA72-4升高;
男性前列腺癌主要是PSA升高,特别是游离PSA升高更为明显。
1、癌胚抗原
癌胚抗原是一个广谱性肿瘤标志物,它能向人们反映出多种肿瘤的存在,对大肠癌、乳腺癌和肺癌的疗效判断、病情发展、监测和预后估计是一个较好的肿瘤标志物,但其特异性不强,灵敏度不高,对肿瘤早期诊断作用不明显。出现癌胚抗原偏高时并不代表你患有癌症,正常血液内也含有癌胚抗原,到医院做一个全面的防癌体检,你会发现身体倍棒!检验医学网
2、甲胎蛋白
AFP是由卵黄囊及胚胎肝产生的一种分子量为70 000的糖蛋白,出生后水平下降,6个月时低于16μg/L,一年后维持正常成人值(< 5μg/L)。
肝细胞性肝癌发生时明显升高,是诊断肝细胞性肝癌的常用指标,标准为高于500μg/L,阳性诊断率可达70%~90%。
卵巢癌、20%胃癌或胰腺癌、5%结直肠癌或肺癌均亦可发现血清/血浆AFP水平升高,但是,升高水平均不及原发性肝癌患者。
怀孕时可一时性升高,慢性肝炎及肝硬化患者血清/血浆内经常在中等水平。
3、前列腺特异性抗原
前列腺特异抗原是用于前列腺良性与恶性疾病诊断与鉴别诊断的重要指标。前列腺肥大与前列腺炎这两种良性疾病,也会造成前列腺特异性抗原升高。如果 前列腺特异性抗原浓度过高时,发生前列腺癌的机会就会增加,需要定期检查,预防疾病发生。
4、需要注意
肿瘤标志物升高不一定就是恶性肿瘤,需要具体情况具体分析。这主要是因为肿瘤标志物只是诊断肿瘤的辅助指标,目前我们还没有发现具有100%特异性的肿瘤标志物,所以如果看到指标升高检查者又没有明显症状时,检查者首先不要恐慌,然后定期监测最好是两周或1个月后进行复查,如果指标没有明显变化,这种升高可能是一过性或代谢异常引起的;如继续升高,则还需要进一步进行CT、B超等检查,并结合临床症状,才能确诊。

尿常规指标
1、尿蛋白
有一些是生理性的蛋白尿,但是出现“+”多数意味着肾脏或者全身疾病引起的异常,您需要做两件事:第一,做24小时蛋白定量检查;第二,找肾脏内科大夫。
(1) 生理性蛋白尿
①功能件蛋白尿:剧烈运动、高热、寒冷、神经紧张等引起的蛋白尿,蛋白定性一般不超过一个“+",多由于肾缺血、肾血管痉挛或充血导致肾小球通透性增加所致。②体位性蛋白尿:脊柱前凸或长时间站立时,在肾静脉受压导致肾静脉压升高.通过肾小球滤过的蛋白质吸收不良引起,体位性蛋白尿定性试验有时高达“++”,此种蛋白尿经卧床休息后可消失,多见与儿童和青年。部分病例是早期肾炎的反映。③摄食性蛋白尿:如注射小分子量蛋白质或一次食人大量蛋白质。
(2) 病理性蛋白尿:
①小球疾病:如急性肾小球肾炎、狼疮性肾炎、过敏性紫癜肾炎、糖尿病肾病等。②肾小管疾病:如活动性肾盂肾炎、间质性肾炎、妊娠高血压综合征、重金属(汞、镉、铋。中毒及应用某些药物等。③肾脏病变同时累及肾小球和肾小管时,尿中低分子和高分子蛋白质均大量增多,是肾功能不全的指征,见于慢性肾小球肾炎、慢性肾盂肾炎等。④严重泌尿系感染、急性溶血性疾病、多发性骨髓瘤、巨球蛋白血症等。检验医学
除了看医生,你还得?
1、多吃水果,疏菜、赤小豆、红枣,禁食辛辣刺激性食品,豆制品及发物(海鲜,公鸡,虾,蟹);
2、少用肾毒*药性**,如一定要使用药物,需要向医生说明情况,遵照医嘱,选择对肾毒性较小的药物。
2、尿糖
出现“+”首先要检测糖尿病,赶紧去找内分泌大夫。但是也有一部分人血糖正常而尿糖异常,我们称为肾性糖尿或者应激性的糖尿。
(1)生理性糖尿:生理性糖尿是由于肾小球滤过增加,肾小管相对吸收减少所致,见于一次摄人大量糖类,静脉注射葡萄糖、精神过度紧张、情绪激动、妊娠等。检
验医学网
(2)病理性糖尿:①糖尿病。②肾性糖尿:见于家族性糖尿、慢性肾炎、肾病综合征、新生儿糖尿等。③其他:甲状腺功能亢进、肾上腺肿瘤、颅脑外伤、脑血管意外、垂体瘤、急性心肌梗死等也可出现尿糖阳性.尿糖检测的假阳性或假阴性:尿液被强氧化剂、双氧水等污染时可产生尿糖假阳性c大量水杨酸盐、高比重尿、尿酮体>400 mg/L或久置的标本可引起尿糖假阴性,应特别注意高浓度维生素C对葡萄糖造成的假阴性。
3、尿酮体医
标本不新鲜会出现“+”,肚子饿久了会出现“+”,严重的糖尿病也会出现“+”,找内分泌科大夫。
(1)糖尿病酮症酸中毒:本病一般尿酮的升高先于血酮,故尿酮检查对诊断重症糖尿病极为重要。
(2)非糖尿性疾病:严重饥饿、剧烈呕吐、严重腹泻、脱水、子痫、营养不良、剧烈运动、全身麻醉、肾小管功能不全等病人,因碱质丢失过多、有机酸相对增多,可大量缩合成酮体,由尿中排出,使酮体呈阳性。
4、上皮细胞及管型
肾实质损害时,如肾小球肾炎,可见较多的肾小管上皮细胞,肾小管上皮细胞的出现与肾小管坏死及肾移植排斥反应和间质肾炎有关。泌尿系统炎症时,还可见较多鳞状上皮细胞和移行上皮细胞。检验医学网
出现管型表示肾实质损害,见于急性或慢性肾小球肾炎、肾功能衰竭等。出现红细胞管型,提示肾性出血,可见于急性肾小球肾炎、肾出血、急性肾小球坏死、肾梗死、恶性高血压等。出现白细胞管型,提示肾实质有细菌感染性病变,如急性肾盂肾炎、肾脓肿等,特别有助于肾盂肾炎与膀胱炎鉴别,后者为阴性。颗粒管型,正常人尿中无粗颗粒管型。细颗粒管型可偶见于运动后,颗粒管型的出现和增多,提示肾脏有实质性病变,表明肾疾病的恶化或进入晚期。
蜡样管型的出现提示肾小管有严重病变,预后差,如慢性肾小球。肾炎晚期、尿毒症、肾功能不全等。出现脂肪管型提示肾小管损伤、肾小管上皮细胞发生脂肪变性,如亚急性肾小球肾炎、慢性肾小球肾炎、中毒性肾病等,尤其多见于肾病综合征。
5、尿比重
个体变化程度较大,是反映肾脏浓缩功能的。
(1)尿比重升高:表示尿液浓缩,见于①生理性:禁水、大量出汗等。②病理性:蛋白尿、惊厥、肾脂肪变性、急性肾小球肾炎、心力衰竭、高热、脱水、周围循环障碍及使用造影剂等。
(2)尿比重降低:表示肾浓缩功能减退,见于①生理性:如大量饮水。②病理性:尿崩症、慢性肾炎、尿毒症、急性肾炎多尿期、原发性醛固酮增多症、胶原性疾病、蛋白营养不良等。等张尿:肾实质有严重损害时,尿比重一般固定在1.010左右,呈等张尿,主要见于尿毒症。
6、尿白细胞
如果是“+”或者数值超过参考值,就是泌尿系感染了。
>5个/高倍镜视野即为镜下脓尿。增多:主要见于泌尿系统的感染,如肾盂肾炎、膀胱炎、尿道炎等;也可见于泌尿系统邻近器官疾病,如前列腺炎、阴道炎、盆腔炎等。
7、尿红细胞
出现“+”就是所谓的“血尿”了,其原因非常众多,也经常让泌尿外科医生抓耳挠腮不得其解。但是都要仔细寻求根源。前面说了,一定要排除肿瘤引起血尿的可能性,尤其是老年人。
>3个/高倍镜视野即为镜下血尿。增多:见于泌尿系统的炎症、肿瘤、结石等。如以形态异常的红细胞为主,提示肾性疾病,但也见于全身性疾病,如特发性血小板减少性紫癜、血友病、再生障碍性贫血、系统性红斑狼疮等,以及泌尿系统邻近器官的疾病,如前列腺炎、盆腔炎等。女性病人月经期及月经期前后的几天中,都可出现红细胞,此为生理性,应注意排除。
为了拿到一张准确的化验报告,
在化验前需要做哪些准备工作?
通常患者口中的化验到底有哪些呢?
血液、尿液、粪便、痰液、精液、白带、前列腺液、胸水、腹水、腹透液、脑脊液、穿刺液、导管、分泌物......
和患者息息相关的主要是哪些?下面重点介绍一下。
患者状态
- 一般需在安静状态下采集样本。
- 高度紧张的状态时,可使血红蛋白、白细胞增高。
- 劳累或受冷等刺激、也可见白细胞的增高。
- 运动影响可分暂时和持续性两类,采血前应有10分钟休息。
体位
体位影响血液循环,例如由卧位改为站位,血浆白蛋白浓度增大。为减少这种影响,采血病人的体位应相对固定,门诊一般采用坐位采血;住院病人可选取卧位采血。
某些特殊项目,如图所示,采用哪种体位遵照医生要求就可以。

时间
采样时间也是有讲究的。
由于病人的生物规律,尤其是女性患者做激素水平分析,例如女性生殖激素与月经周期密切相关,故采血应在相同时间进行,不能这次月经期,下次另一个时间段。此类项目采样时间如图:

脂血
分病理性和生理性,产生的原因:
- 抽血前食入富含脂肪的食物。
- 空腹患者有脂血现象,属于病理因素。
甘油三酯过高,血浆或血清呈浑浊状。
胆固醇含量高,血清或血浆外观没有变化。
有乳糜微粒会在血清液面浮上一层奶油状物质。

血液化验
- 患者要配合做身份确认:口头确认、采血凭证、医保卡/发票确认 。
- 抽血化验请有序排队,避免采血“张冠李戴”。
- 患者采血时应配合工作人员,相信医生,不要过于紧张。
- 采血后应正确按压5分钟,凝血功能不好者适当延长5-10分钟方可止血,切勿揉搓或边压边看。

尿液化验注意事项
- 晨尿:留取晨起后第1次尿液的中段尿放入清洁容器送检。
- 尿量要充足:尿液分析需要10ml尿液,须留取半杯以上。
- 尿液2小时内送往化验室检测。
- 女性患者是否在月经期,若在月经期则不宜留尿标本。


粪便化验
- 自然排便采集法:粪便中不要混入尿液、水分等。
- 成形粪便:挑取5克左右,约2粒花生米大小或1平勺。
- 水样便:留取2ml以上,占管长的1/3。
- 无法排便者:将开塞露插入肛门4~5cm(幼儿2~3cm)处,刺激排便,但动作要轻柔。
排便后,留取脓血黏液等病理成分送检,若无病理成分,可多部位取材。
1小时内送检,不要使用尿不湿、吸水性材料留取粪便。
粪便隐血试验:化验前3天内禁食肉类、肝类、血类食物,并禁服铁剂。
痰液化验
- 自然咳痰法:以晨痰为佳,留痰前先用冷开水或无菌生理盐水反复漱口(有义齿的病人取下义齿),用力咳出气管深处痰液(可轻拍背部),吐入无菌痰杯中。结核分枝杆菌应收集24h痰液以提高阳性率。
- 应在服用抗生素药物之前收集痰液,请勿混入唾液、口水或鼻涕。
男性精液化验
- 采集精液前必须禁欲(房事/*交性**),包括无遗精或手淫。一般情况下,25岁以下禁欲3天,25-35岁以下禁欲5天,35-45岁以下禁欲7天。
- 采集精液前应排净尿液。
- 晨起采精最佳,应将一次射出的精液全部收集于无菌杯中送检,禁止使用纸巾或避孕套收集精液。
- 采精前将手和生殖器,特别是阴茎*头龟**用温水洗净,环境应安静无干扰。
- 精液应1小时内送检。在运送过程中,应保持精液温度在25-35℃,冬天则应将精液放在内衣口袋内贴身运送。
- 因精子生成日间变动较大,对于少精患者,不能仅凭一次检查结果做确诊,一般应间隔1-2周检查一次,连续检查2-3次。
小贴士
- 化验报告的领取请以检验科医生告知为准,而就诊医生告知的时间仅供参考。
- 如果你既有20分钟的常规化验,又有1小时的生化检验,请至少在40分钟以后再去查找自己的报告。
- 务必等所有化验报告拿齐了,再去找医生看病。
- 不要找检验医生解释检验结果,检验报告需要根据您的病情来判断,最了解您病情的是您的就诊医生。
来源:湘南学院附属医院健康管理中心、医遛健康、摄图网、检验医学网,平台仅作分享,若有侵权请联系我们。